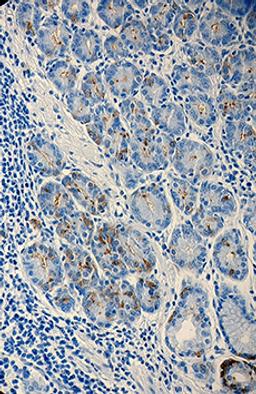

Product & ReviewsAntibodies
Anti-BG-4
Product Details
- Cat. No.
- 922102
- Type
- Primary Antibody
- Clonality
- Monoclonal
- Host
- Mouse

The supplier does not provide quotations for this antibody through SelectScience. You can search for similar antibodies in our Antibody Directory.
Description
Anti-BG-4; Clone: 17-206; Reactivity: Human; Apps: IHC; Size: 1 ml
Biological Information
- Clonality: Monoclonal
- Host: Mouse
- Reactivity: Human
- Clone: 17-206
- Conjugate: Ascites
- Isotype: Mouse IgG3
Handling
- Quantity: 1 ml
- Storage: 2°C-8°C
Applications
- Immunohistochemistry (IHC)